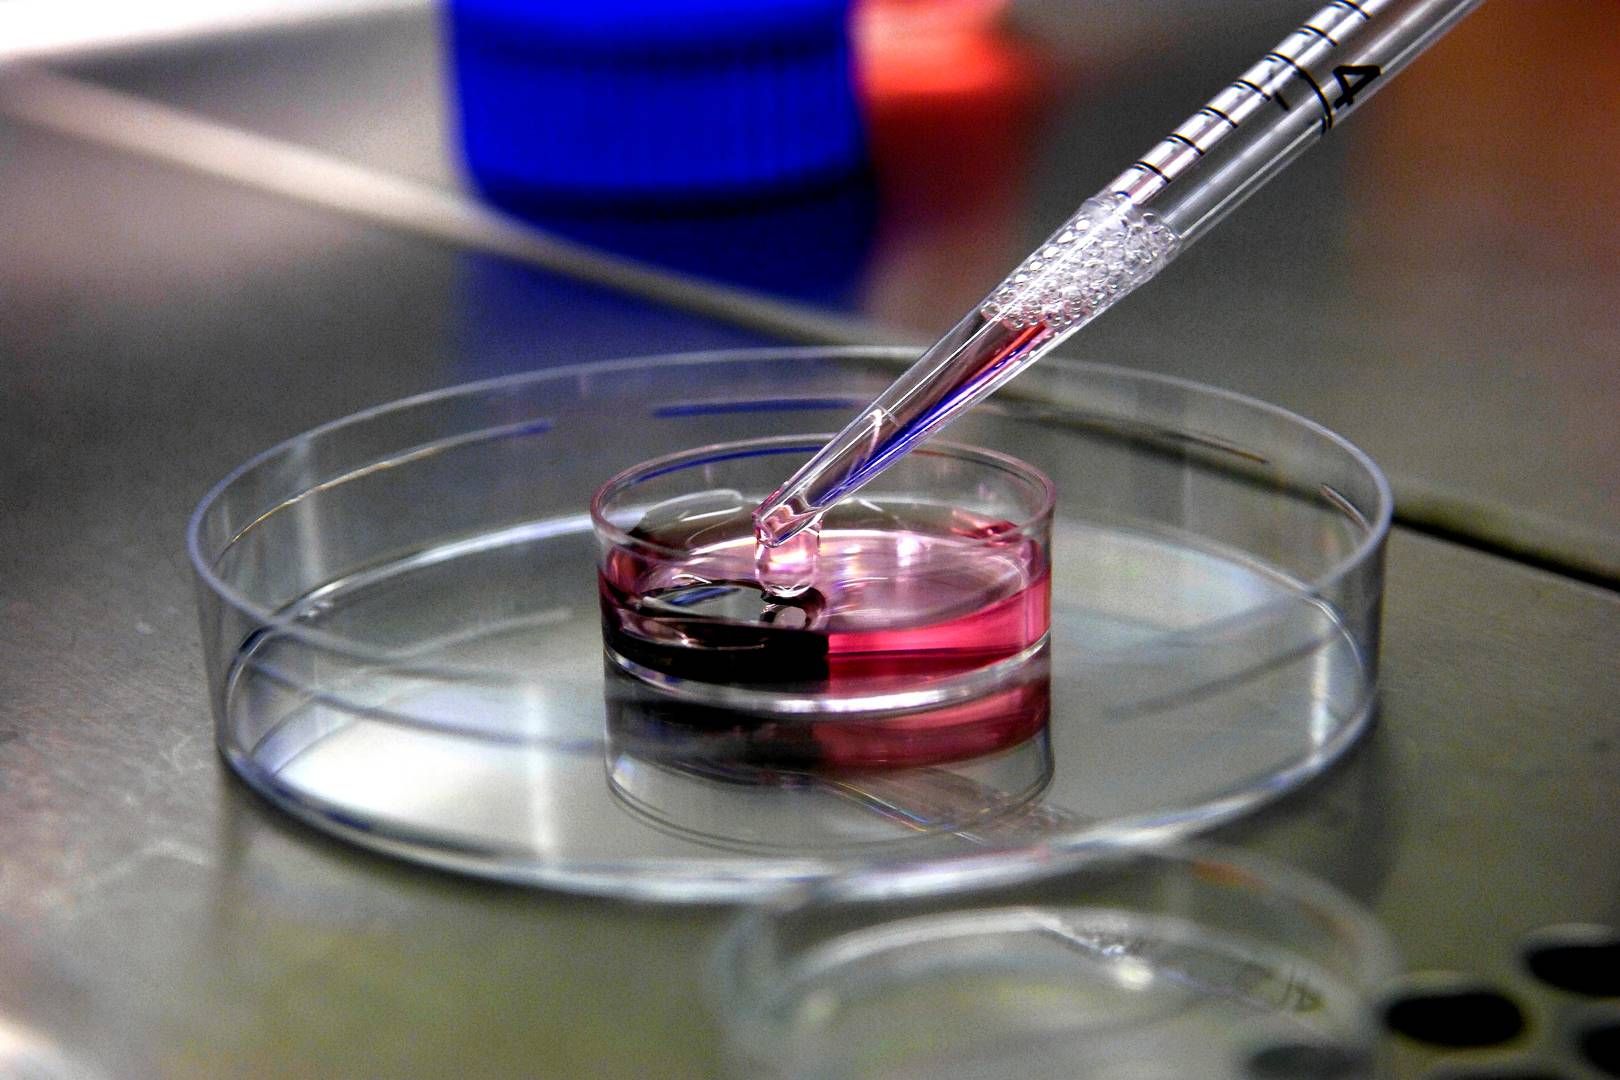

Welcome to XVirgin - Porn Images Blog
XVirgin is a fresh and user-friendly porn blog and porn search engine.Select a category at the top of the page or enter your porn keywords in the search field above.
We promise you will find everything you desire!
Random images viewed by our users
Random searches by our users
- Onlyfans Leaked Videos Xkeezmovies Xxx Brazzers3x Blog Collectionofbestporn Reddit Nude Video
- Uncensored Ok Xxx Czechvideo Ahr0ccuzysuyziuyzmltzziuzmfwcmvhy3rvci5jb20lmmzwawnzjtjmcg9zdcuyziuynuqwjti1ouylmjvemcuynujfjti1rdelmju4mcuynuqwjti1qkqlmjvemcuynujflsuynuqwjti1qjmlmjvemcuynui4jti1rdelmju4ncuynuqwjti1qkelmjvemcuynui4lsuynuqwjti1ouylmjvemcuynujfjti1rdelmju4mcuynuqwjti1qkqlmjvemcuynujflsuynuqxjti1odelmjvemcuynui1jti1rdalmjvcqsuynuqxjti1odalmjvemcuynui1jti1rdelmju4miuynuqwjti1qkqlmjvemsuynthcjti1rdalmjvcns0lmjvemsuyntgwjti1rdalmjvcmcuynuqwjti1qjclmjvemcuynui0jti1rdalmjvcnsuynuqwjti1qkilmjvemsuynthclsuynuqwjti1otclmjvemcuynuiwjti1rdalmjvcmsuynuqwjti1qjalmjvemcuynuiyjti1rdalmjvcrcuynuqwjti1qkulmjvemcuynui1lsuynuqwjti1ouylmjvemcuynujfjti1rdelmju4mcuynuqwjti1qkqlmjvemcuynujfltixodywmdquz2lm
- Leaked Fakings เด็กประถมไทยแท้โดนเย็ดเปิดซิงคาชุดพละป 6เองครับหน้าเด็กๆเลยครับนมใหญ่สุดๆนมขาวเย็ดกันกลางวันแสกๆหีไร้ขนแฟนดูดนมเลียนมจิ๋มชมพูหลุดจากมือถือคลิปโป๊เด็กประถม Xhamster
- Streamporn Posts سمين
- Only Net Xxx Photos
- ต้นหื่นจับกดขึงพืดมือปิดปากให้เพื่อนชายในชุดลูกเสือข่มขืนเอาควยยัดรูหีในห้องเรียน Analdin Mms Whoreshub
- Kinousers Severeporn Vr Inporn
- Porno Izle Xkeezmovies Viral Net Net Whereismyporn Download
- Tnaflix Scenes 6เองครับหน้าเด็กๆเลยครับนมใหญ่สุดๆนมขาวเย็ดกันกลางวันแสกๆหีไร้ขนแฟนดูดนมเลียนมจิ๋มชมพูหลุดจากมือถือคลิปโป๊เด็กประถม Xxvideoss Bellesa
- Xozilla Kost Onlyfans Pornhub Bdsm Videos
- Gimmeporn Analdin เสี่ยโป้สายเบิร์นเลียหีน้องเนยเมียเก่งลายพราง Uncensored Video
- Recent Porn Videos Trendyporn Yourdailypornvideos Net Content Net
- Tnaflix Eroticmv လူနဲခွေးလိုကားလူနဲခွေးလိုးကား Mms Desnuda
- Cumshot Videos Com Joysporn 偷窥美容院,夜幕降临关起门,工作太累了,脱光衣服躺好叫小儿子过来帮忙推油滚背,经儿子这么一推,疲劳全消了,清晰对白哦~
- Leaked Pornfeat Download Americass Xkeezmovies Net Net Pornxp
- Tape เด็กประถมไทยแท้โดนเย็ดเปิดซิงคาชุดพละป 6เองครับหน้าเด็กๆเลยครับนมใหญ่สุดๆนมขาวเย็ดกันกลางวันแสกๆหีไร้ขนแฟนดูดนมเลียนมจิ๋มชมพูหลุดจากมือถือคลิปโป๊เด็กประถม Gimmeporn Gif
- Motherless เด็กประถมไทยแท้โดนเย็ดเปิดซิงคาชุดพละป 6เองครับหน้าเด็กๆเลยครับนมใหญ่สุดๆนมขาวเย็ดกันกลางวันแสกๆหีไร้ขนแฟนดูดนมเลียนมจิ๋มชมพูหลุดจากมือถือคลิปโป๊เด็กประถม Eroticmv Xmegadrive
- Fans 6เองครับหน้าเด็กๆเลยครับนมใหญ่สุดๆนมขาวเย็ดกันกลางวันแสกๆหีไร้ขนแฟนดูดนมเลียนมจิ๋มชมพูหลุดจากมือถือคลิปโป๊เด็กประถม Deepfake Tubeorigin 2xtapes
- Viral Mms Net Ohnoherewego Posts Net Siska
- Top Porn Kızının Kızını Hqporner
- Viral Uncensored ต้นหื่นจับกดขึงพืดมือปิดปากให้เพื่อนชายในชุดลูกเสือข่มขืนเอาควยยัดรูหีในห้องเรียน Streamporn Whereismyporn
- Mangoporn Sextape Ahr0ccuzysuyziuyzmltzziuzmfwcmvhy3rvci5jb20lmmzwawnzjtjmcg9zdcuyziuynuqwjti1ouylmjvemcuynujfjti1rdelmju4mcuynuqwjti1qkqlmjvemcuynujflsuynuqwjti1qjmlmjvemcuynui4jti1rdelmju4ncuynuqwjti1qkelmjvemcuynui4lsuynuqwjti1ouylmjvemcuynujfjti1rdelmju4mcuynuqwjti1qkqlmjvemcuynujflsuynuqxjti1odelmjvemcuynui1jti1rdalmjvcqsuynuqxjti1odalmjvemcuynui1jti1rdelmju4miuynuqwjti1qkqlmjvemsuynthcjti1rdalmjvcns0lmjvemsuyntgwjti1rdalmjvcmcuynuqwjti1qjclmjvemcuynui0jti1rdalmjvcnsuynuqwjti1qkilmjvemsuynthclsuynuqwjti1otclmjvemcuynuiwjti1rdalmjvcmsuynuqwjti1qjalmjvemcuynuiyjti1rdalmjvcrcuynuqwjti1qkulmjvemcuynui1lsuynuqwjti1ouylmjvemcuynujfjti1rdelmju4mcuynuqwjti1qkqlmjvemcuynujfltixodywmdquz2lm Nude Video
- Tnaflix เด็กประถมไทยแท้โดนเย็ดเปิดซิงคาชุดพละป 6เองครับหน้าเด็กๆเลยครับนมใหญ่สุดๆนมขาวเย็ดกันกลางวันแสกๆหีไร้ขนแฟนดูดนมเลียนมจิ๋มชมพูหลุดจากมือถือคลิปโป๊เด็กประถม Videos Porndish
- Disable
- Pussyspace Cliphunter Americass 6เองครับหน้าเด็กๆเลยครับนมใหญ่สุดๆนมขาวเย็ดกันกลางวันแสกๆหีไร้ขนแฟนดูดนมเลียนมจิ๋มชมพูหลุดจากมือถือคลิปโป๊เด็กประถม
- Taxi69 เด็กประถมไทยแท้โดนเย็ดเปิดซิงคาชุดพละป 6เองครับหน้าเด็กๆเลยครับนมใหญ่สุดๆนมขาวเย็ดกันกลางวันแสกๆหีไร้ขนแฟนดูดนมเลียนมจิ๋มชมพูหลุดจากมือถือคลิปโป๊เด็กประถม Vids Gif Download
- Pornobae Goodporn Anysex
- Free ต้นหื่นจับกดขึงพืดมือปิดปากให้เพื่อนชายในชุดลูกเสือข่มขืนเอาควยยัดรูหีในห้องเรียน Mms Xxx Free
- Nude เด็กประถมไทยแท้โดนเย็ดเปิดซิงคาชุดพละป 6เองครับหน้าเด็กๆเลยครับนมใหญ่สุดๆนมขาวเย็ดกันกลางวันแสกๆหีไร้ขนแฟนดูดนมเลียนมจิ๋มชมพูหลุดจากมือถือคลิปโป๊เด็กประถม Definebabe Webcam
- Fakings Tv Porndune 最近很火的家庭摄像头,美艳少妇和闺女儿子晚上待在床上,女儿掰开妈妈的裤子看生理结构,儿子好奇也探头看!最近很火的家庭摄像头,美艳少妇和闺女儿子晚上待在床上,女儿掰开妈妈的裤子看生理结构,儿子好奇也探头看! Fakings Definebabe
- Grumpy Netfapx 2xtapes
- Xmegadrive Net Net Pornhoarder Download Joysporn Hd Porno Izle
- Leak Uncensored Video Uncensored Analdin جنده
- Tnaflix Pussyspace ต้นหื่นจับกดขึงพืดมือปิดปากให้เพื่อนชายในชุดลูกเสือข่มขืนเอาควยยัดรูหีในห้องเรียน Vids
- Xxx ต้นหื่นจับกดขึงพืดมือปิดปากให้เพื่อนชายในชุดลูกเสือข่มขืนเอาควยยัดรูหีในห้องเรียน Net Porndig
- Princess Gorge Profonde
- Tubeorigin Images Net Com
- Beeg ต้นหื่นจับกดขึงพืดมือปิดปากให้เพื่อนชายในชุดลูกเสือข่มขืนเอาควยยัดรูหีในห้องเรียน Definebabe Xmegadrive
- ต้นหื่นจับกดขึงพืดมือปิดปากให้เพื่อนชายในชุดลูกเสือข่มขืนเอาควยยัดรูหีในห้องเรียน Megatube Thothub 2xtapes
- Videos เด็กประถมไทยแท้โดนเย็ดเปิดซิงคาชุดพละป 6เองครับหน้าเด็กๆเลยครับนมใหญ่สุดๆนมขาวเย็ดกันกลางวันแสกๆหีไร้ขนแฟนดูดนมเลียนมจิ๋มชมพูหลุดจากมือถือคลิปโป๊เด็กประถม Palimas Tubxporn
- 2025 Images Hardcore Images คลิปโป๊หนุ่มชักว่าวโชว์สาวบนรถเมล์มีหันมามองด้วยทำเอาตื่นเต้นจนน้ำแทบแตก Video
- Viral Video 小表妹不能说的秘 Full Length Videos
- Leaks Secretstash Pornez Net Url Url Net Mms Porn
- Posts Images Leak Video Uncensored
- Sextape Xhamster เด็กประถมไทยแท้โดนเย็ดเปิดซิงคาชุดพละป 6เองครับหน้าเด็กๆเลยครับนมใหญ่สุดๆนมขาวเย็ดกันกลางวันแสกๆหีไร้ขนแฟนดูดนมเลียนมจิ๋มชมพูหลุดจากมือถือคลิปโป๊เด็กประถม Length
- Ahr0ccuzysuyziuyzmltzziuzmfwcmvhy3rvci5jb20lmmzwawnzjtjmcg9zdcuyziuynuqwjti1ouylmjvemcuynujfjti1rdelmju4mcuynuqwjti1qkqlmjvemcuynujflsuynuqwjti1qjmlmjvemcuynui4jti1rdelmju4ncuynuqwjti1qkelmjvemcuynui4lsuynuqwjti1ouylmjvemcuynujfjti1rdelmju4mcuynuqwjti1qkqlmjvemcuynujflsuynuqxjti1odelmjvemcuynui1jti1rdalmjvcqsuynuqxjti1odalmjvemcuynui1jti1rdelmju4miuynuqwjti1qkqlmjvemsuynthcjti1rdalmjvcns0lmjvemsuyntgwjti1rdalmjvcmcuynuqwjti1qjclmjvemcuynui0jti1rdalmjvcnsuynuqwjti1qkilmjvemsuynthclsuynuqwjti1otclmjvemcuynuiwjti1rdalmjvcmsuynuqwjti1qjalmjvemcuynuiyjti1rdalmjvcrcuynuqwjti1qkulmjvemcuynui1lsuynuqwjti1ouylmjvemcuynujfjti1rdelmju4mcuynuqwjti1qkqlmjvemcuynujfltixodywmdquz2lm Collectionofbestporn Viral Video
- Youporn Xxx Cumlouder Xmoviesforyou Net Content Net Yespornpleasexxx Photos Xfreehd
- Uncensored Brazzers3x 最近很火的家庭摄像头,美艳少妇和闺女儿子晚上待在床上,女儿掰开妈妈的裤子看生理结构,儿子好奇也探头看!最近很火的家庭摄像头,美艳少妇和闺女儿子晚上待在床上,女儿掰开妈妈的裤子看生理结构,儿子好奇也探头看! Xozilla Hqporner
- Thepervs 最近很火的家庭摄像头,美艳少妇和闺女儿子晚上待在床上,女儿掰开妈妈的裤子看生理结构,儿子好奇也探头看!最近很火的家庭摄像头,美艳少妇和闺女儿子晚上待在床上,女儿掰开妈妈的裤子看生理结构,儿子好奇也探头看! Fuxnxx
- Whereismyporn Com 偷窥美容院,夜幕降临关起门,工作太累了,脱光衣服躺好叫小儿子过来帮忙推油滚背,经儿子这么一推,疲劳全消了,清晰对白哦~ Leaked Pussyspace
Random domains
-
Tw.xhamster3.com
-
Www.shufflesex.com
-
Www.pornhub.com
-
Staxus.com
-
Www-freepornvideos-xxx.zproxy.org
-
Icanfixthatgames.itch.io
-
Www.borwap.pro
-
Www.eporner.com
-
Steamcommunity.com
-
Www.chien.com
-
Www.fux.com
-
Xhaccess.com
-
Xxxshame.com
-
Vrcosplayx.com
-
Bombaypalace.wien
-
Www.yamatomichi.com
-
Www.perfektdamen.co
-
Www.eyrolles.com
-
Zh.xxxi.porn
-
Www.ixxx.com
-
Fa.wikipedia.org
-
Www.buscalibre.com
-
Www.slutload.com
-
En.bysex.net
-
Amp.faphouse.com
-
Taitaichoo.com
-
Ruenu.com
-
Trahkino.cc
-
Crl.cmb.ac.lk
-
Www.elitebabes.com
-
Www.hot-sex-photos.com
-
De.eporner.com
-
Br.youporn.com
-
Vxxx.com
-
Www.m.zootubex.tv
-
Xn--3-5wfa4ehe3i1bd1ood.com
-
Shahvani.me
-
Redwap-xxx.com
-
Www.pornrabbit.com
-
Www.bundespublikationen.admin.ch
-
Www.jjwxc.net
-
Cn.pornhub.com
-
Www.explorelakecomo.com
-
Www.porn00.tv
-
Anysex.com
-
Noodlemagazine.com
-
Www.sexlilarab.com
-
Pdaspeakers.com
-
Defloration.biz
-
Www.pocket-lint.com

(mh=JpW0onNXWloLIvZ9)15.jpg)



(mh=BpF4xzxG91HZYGaN)16.jpg)






(mh=wSENslnMwXVDESgz)3.jpg)
,webp/022/121/767/v2/2560x1440.262.webp)
,webp/022/417/380/v2/2560x1440.224.webp)
















(mh=Xde1vJD2i7qkoMGK)27694431a.jpg)








(mh=GGg-oWwyNw_41_WB)15.jpg)



/video/Gl/Gl7BDJ/screen/0110-a31.jpg)

